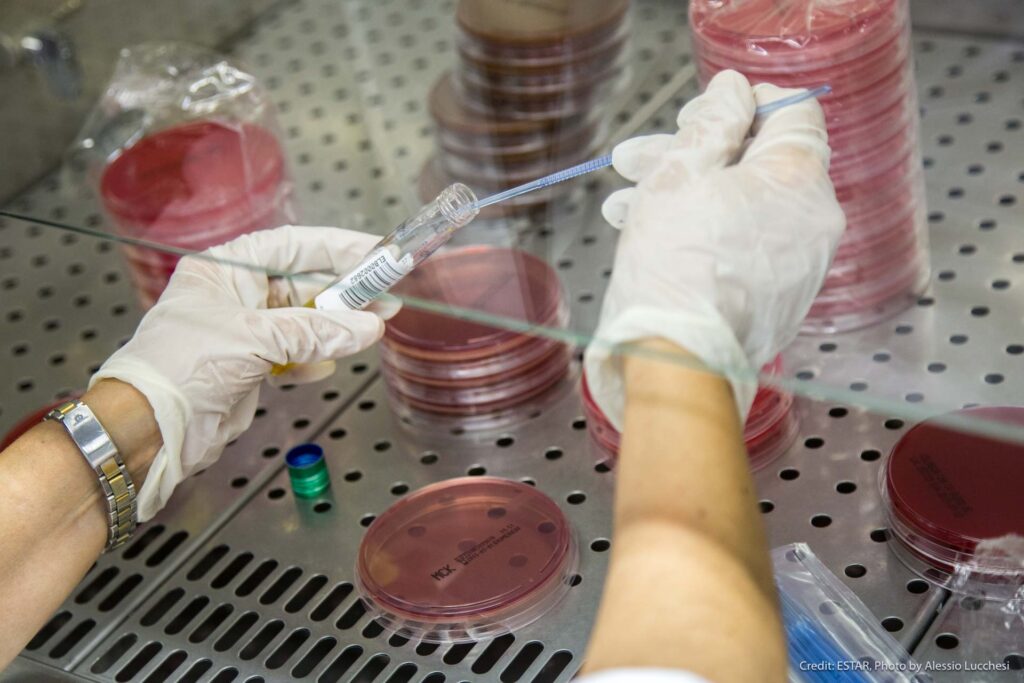

Sono oltre 50 i professionisti Aoup nel ranking mondiale dei ricercatori pubblicato dalla Stanford University
Medicina nucleare e radiologia, malattie cardiovascolari, virologia, endocrinologia e metabolismo, chirurgia, psichiatria, neurologia e neurochirurgia: sono queste le branche specialistiche di area medico-chirurgica “targate Pisa” che si piazzano nelle prime 10 posizioni, facendo un’estrazione per Paese e affiliazione all’Azienda ospedaliero-universitaria pisana o all’Università di Pisa, nel ranking 2024 della Stanford University edito da Elsevier, ossia la classifica annuale degli studiosi profilati nel database Scopus (circa 9 milioni nel mondo), che indica il primo 2% di quelli più citati a livello globale (informazioni bibliometriche aggiornate alla fine dell’anno di citazione 2023). La classifica è basata su parametri quali il numero di pubblicazioni come singolo, primo o ultimo autore e l’indice di citazione (H-index).
Ai primi tre posti fra quelli attualmente in servizio in Aoup (perché nella classifica “pisana” 2024 risultano anche una decina di professionisti non più in Aoup o collocati a riposo), ci sono:
1. Riccardo Lencioni (al 5.839° posto generale e, nello specifico per la medicina nucleare e la diagnostica per immagini, 7° al mondo e 1° in Italia)
2. Raffaele De Caterina per la cardiologia (all’8.403° posto generale, e nello specifico per la cardiologia, 264° nel mondo e 60° in Italia)
3. Daniele Focosi, ospedaliero (al 20.157mo posto generale, e nello specifico per la virologia, 57° nel mondo e 1° in Italia)
In totale, fra quelli attualmente attivi, sono 51 i docenti universitari dei 3 dipartimenti della Scuola di Medicina presenti nella classifica e 6 i professionisti ospedalieri.
Se l’estrazione viene fatta per Dipartimenti universitari (i tre dell’area medica della Scuola di Medicina), vengono fuori 21 docenti del Dipartimento di patologia chirurgica, molecolare e dell’area critica (di cui ai primi tre posti i già citati Lencioni e De Caterina, insieme a Federico Coccolini, 105° al mondo e 7° in Italia per la chirurgia generale), 18 del Dipartimento di medicina clinica e sperimentale (di cui al vertice Rossella Elisei, endocrinologia, Piero Marchetti, diabetologia, e Agostino Virdis, clinica medica), 12 del Dipartimento di ricerca traslazionale (di cui al vertice Fabio Coppedè, genetica medica, Ugo Boggi, chirurgia generale, e Chiara Cremolini, oncologia).
Piena soddisfazione è stata espressa dal presidente della Scuola di Medicina, Emanuele Neri e dai direttori dei tre Dipartimenti dell’Università (Grazia Chiellini, Aldo Paolicchi e Stefano Taddei) secondo i quali il posizionamento di ben 51 docenti, attualmente in servizio attivo, evidenzia l’elevata qualità della ricerca dell’area medica universitaria pisana. Analogo plauso anche dalla direttrice generale dell’Aoup Silvia Briani per la quale questa cospicua rappresentanza, comprensiva anche dei colleghi ospedalieri con una ricerca di altissimo livello, non fa che confermare l’importanza della natura composita di questa Azienda, nell’ottica della necessaria integrazione fra la componente più propriamente dedita alla ricerca e alla formazione con quella che ha un ruolo diretto nel processo assistenziale, con le ricadute sulla salute dei pazienti che sono la cartina al tornasole della sanità di eccellenza.
Fonte: Ufficio stampa Aou Pisa - Scuola di Medicina